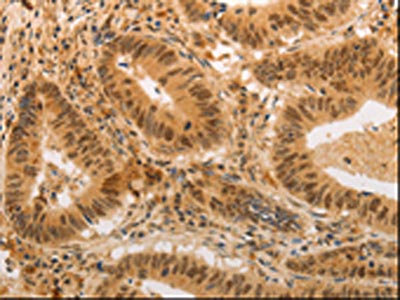

ADRA1B Antibody
-
中文名稱:ADRA1B兔多克隆抗體
-
貨號(hào):CSB-PA946457
-
規(guī)格:¥1100
-
圖片:
-
The image on the left is immunohistochemistry of paraffin-embedded Human colon cancer tissue using CSB-PA946457(ADRA1B Antibody) at dilution 1/20, on the right is treated with synthetic peptide. (Original magnification: ×200)
-
The image on the left is immunohistochemistry of paraffin-embedded Human gastic cancer tissue using CSB-PA946457(ADRA1B Antibody) at dilution 1/20, on the right is treated with synthetic peptide. (Original magnification: ×200)
-
Gel: 10%SDS-PAGE, Lysate: 40 μg, Lane: Human lung cancer tissue, Primary antibody: CSB-PA946457(ADRA1B Antibody) at dilution 1/550, Secondary antibody: Goat anti rabbit IgG at 1/8000 dilution, Exposure time: 1 minute
-
-
其他:
產(chǎn)品詳情
-
Uniprot No.:
-
基因名:
-
別名:ADRA1B; Alpha-1B adrenergic receptor; Alpha-1B adrenoreceptor; Alpha-1B adrenoceptor
-
宿主:Rabbit
-
反應(yīng)種屬:Human,Mouse,Rat
-
免疫原:Synthetic peptide of Human ADRA1B
-
免疫原種屬:Homo sapiens (Human)
-
標(biāo)記方式:Non-conjugated
-
抗體亞型:IgG
-
純化方式:Antigen affinity purification
-
濃度:It differs from different batches. Please contact us to confirm it.
-
保存緩沖液:-20°C, pH7.4 PBS, 0.05% NaN3, 40% Glycerol
-
產(chǎn)品提供形式:Liquid
-
應(yīng)用范圍:ELISA,WB,IHC
-
推薦稀釋比:
Application Recommended Dilution ELISA 1:1000-1:5000 WB 1:200-1:1000 IHC 1:25-1:100 -
Protocols:
-
儲(chǔ)存條件:Upon receipt, store at -20°C or -80°C. Avoid repeated freeze.
-
貨期:Basically, we can dispatch the products out in 1-3 working days after receiving your orders. Delivery time maybe differs from different purchasing way or location, please kindly consult your local distributors for specific delivery time.
-
用途:For Research Use Only. Not for use in diagnostic or therapeutic procedures.
相關(guān)產(chǎn)品
靶點(diǎn)詳情
-
功能:This alpha-adrenergic receptor mediates its action by association with G proteins that activate a phosphatidylinositol-calcium second messenger system. Its effect is mediated by G(q) and G(11) proteins. Nuclear ADRA1A-ADRA1B heterooligomers regulate phenylephrine (PE)-stimulated ERK signaling in cardiac myocytes.
-
基因功能參考文獻(xiàn):
- ADRA1B rs10070745 was significantly associated with vasoconstrictor responses. PMID: 27089938
- Receptor Species-dependent Desensitization Controls KCNQ1/KCNE1 K+ Channels as Downstream Effectors of Gq Protein-coupled Receptors.( PMID: 27834678
- protein kinase C modulates alpha1B-adrenergic receptor transfer to late endosomes and that Rab9 regulates this process and participates in G protein-mediated signaling turn-off. PMID: 28082304
- eIF3f/alpha adrenergic receptor interaction PMID: 26497985
- heteromeric receptor complexes between alpha1A-AR and CXCR4 and between alpha1B-AR and CXCR4 are constitutively expressed in rat and human vascular smooth muscle cells; the quaternary structure of the receptor complex is important for signaling and contraction PMID: 25775528
- alpha1B-AR signals through calcium, ERK1/2 and p38 only when located in the membrane and the signals disappear by membrane disruption. PMID: 23717684
- A rare ADRA1B haplotype composed of six single nucleotide polymorphism(SNP)s is associated with attention deficit hyperactivity disorder (ADHD). PMID: 23052569
- Noradrenaline facilitated cell proliferation by regulation of potassium currents in human osteoblasts via G(i/o) -protein-coupled alpha(1B) -adrenoceptors, not via coupling to Gq-proteins PMID: 23061915
- Through beta-D receptor heteromers dopamine inhibits adrenergic receptor signaling and blocks the synthesis of melatonin induced by adrenergic receptor ligands. PMID: 22723743
- Data show that sphingosine 1-phosphate can induce alpha1B-adrenergic receptor internalization and that its autocrine/paracrine generation is relevant for internalization induced by IGF-I. PMID: 22019450
- alpha1b and alpha2c AR is over-expressed in basal-like breast tumours of poor prognosis PMID: 21298476
- The mRNA expression of alpha1b-AR subtypes in bladder detrusor and posterior urethra was significantly lower in the inflammation group than in controls. PMID: 21223784
- A-kinase anchoring protein (AKAP)-Lbc anchors a PKN-based signaling complex involved in alpha1-adrenergic receptor-induced p38 activation. PMID: 21224381
- These results are the first to demonstrate alpha1-ARs on human coronary ECs and indicate that the alpha1B subtype is predominant. PMID: 20857090
- the alpha(1B)-AR has differential effects on the phosphorylation status of the STAT3 pathway and may not be as prohypertrophic as the other two subtypes. PMID: 12695539
- heterodimerization with alpha1B-adrenergic receptors controls cell surface expression of alpha1D-adrenergic receptors PMID: 14736874
- the alpha(1B)-adrenoreceptor has a role in the inhibition of migration of human aortic smooth muscle cells PMID: 15220331
- alpha(1B)-adrenergic receptor expression causes a cell cycle progression and may induce transformation in sensitive cell lines. PMID: 15297446
- Human ureter was endowed with each alpha1 AR subtype, although alpha1D and alpha1A ARs were prevalent over alpha1B ARs PMID: 15690361
- These results indicate that the thio-acylation status of the alpha1b-adrenoceptor does not regulate G protein activation whereas thio-acylation of Galpha11 plays a key role in activation by the receptor. PMID: 16297597
- Ezrin directly interacts with the alpha1b-adrenergic receptor and plays a role in receptor recycling. PMID: 16352594
- the ADRA1B is able to form oligomeric rather than only simple dimeric complexes and disruption of effective oligomerization by introducing mutations into transmembrane domain IV has profound consequences for cell surface delivery and function PMID: 17220353
- alpha1B-ARs are the major alpha1-AR subtype expressed in DU145, PC3, and all TRAMP cell lines, but most of the receptor is localized in intracellular compartments in a nonfunctional state, which can be rescued upon prolonged incubation with any ligand. PMID: 17365508
- expression in distal ureter significantly higher than in proximal and mid ureter PMID: 17973108
- ADRA1B expression was increased in end stage renal disease. Functional receptor changes mediated vascular hypersensitivity to phenylephrine. PMID: 18257748
- Pharmacological profile of alpha 1B-adrenoceptors for ketanserin is strongly influenced by the assay conditions. PMID: 18336813
- These findings demonstrate differences in internalization between the alpha1a- and alpha1b-AR and provide evidence that the lack of significant endocytosis of the alpha1a-AR is linked to its poor interaction with beta-arrestins as well as with AP50. PMID: 18523139
- Functional alpha1- and beta2-adrenergic receptors in human osteoblasts. PMID: 19334040
- Report alpha1A and alpha1B subtypes are both present in human myocardium, but alpha1D binding is not, and the alpha1 subtypes are not downregulated in heart failure. PMID: 19919991
顯示更多
收起更多
-
亞細(xì)胞定位:Nucleus membrane; Multi-pass membrane protein. Cell membrane; Multi-pass membrane protein. Cytoplasm. Membrane, caveola. Note=Location at the nuclear membrane facilitates heterooligomerization and regulates ERK-mediated signaling in cardiac myocytes. signaling in cardiac myocytes. Colocalizes with GNAQ, PLCB1 as well as LAP2 at the nuclear membrane of cardiac myocytes.
-
蛋白家族:G-protein coupled receptor 1 family, Adrenergic receptor subfamily, ADRA1B sub-subfamily
-
數(shù)據(jù)庫(kù)鏈接:
Most popular with customers
-
YWHAB Recombinant Monoclonal Antibody
Applications: ELISA, WB, IHC, IF, FC
Species Reactivity: Human, Mouse, Rat
-
Phospho-YAP1 (S127) Recombinant Monoclonal Antibody
Applications: ELISA, WB, IHC
Species Reactivity: Human
-
-
-
-
-
-